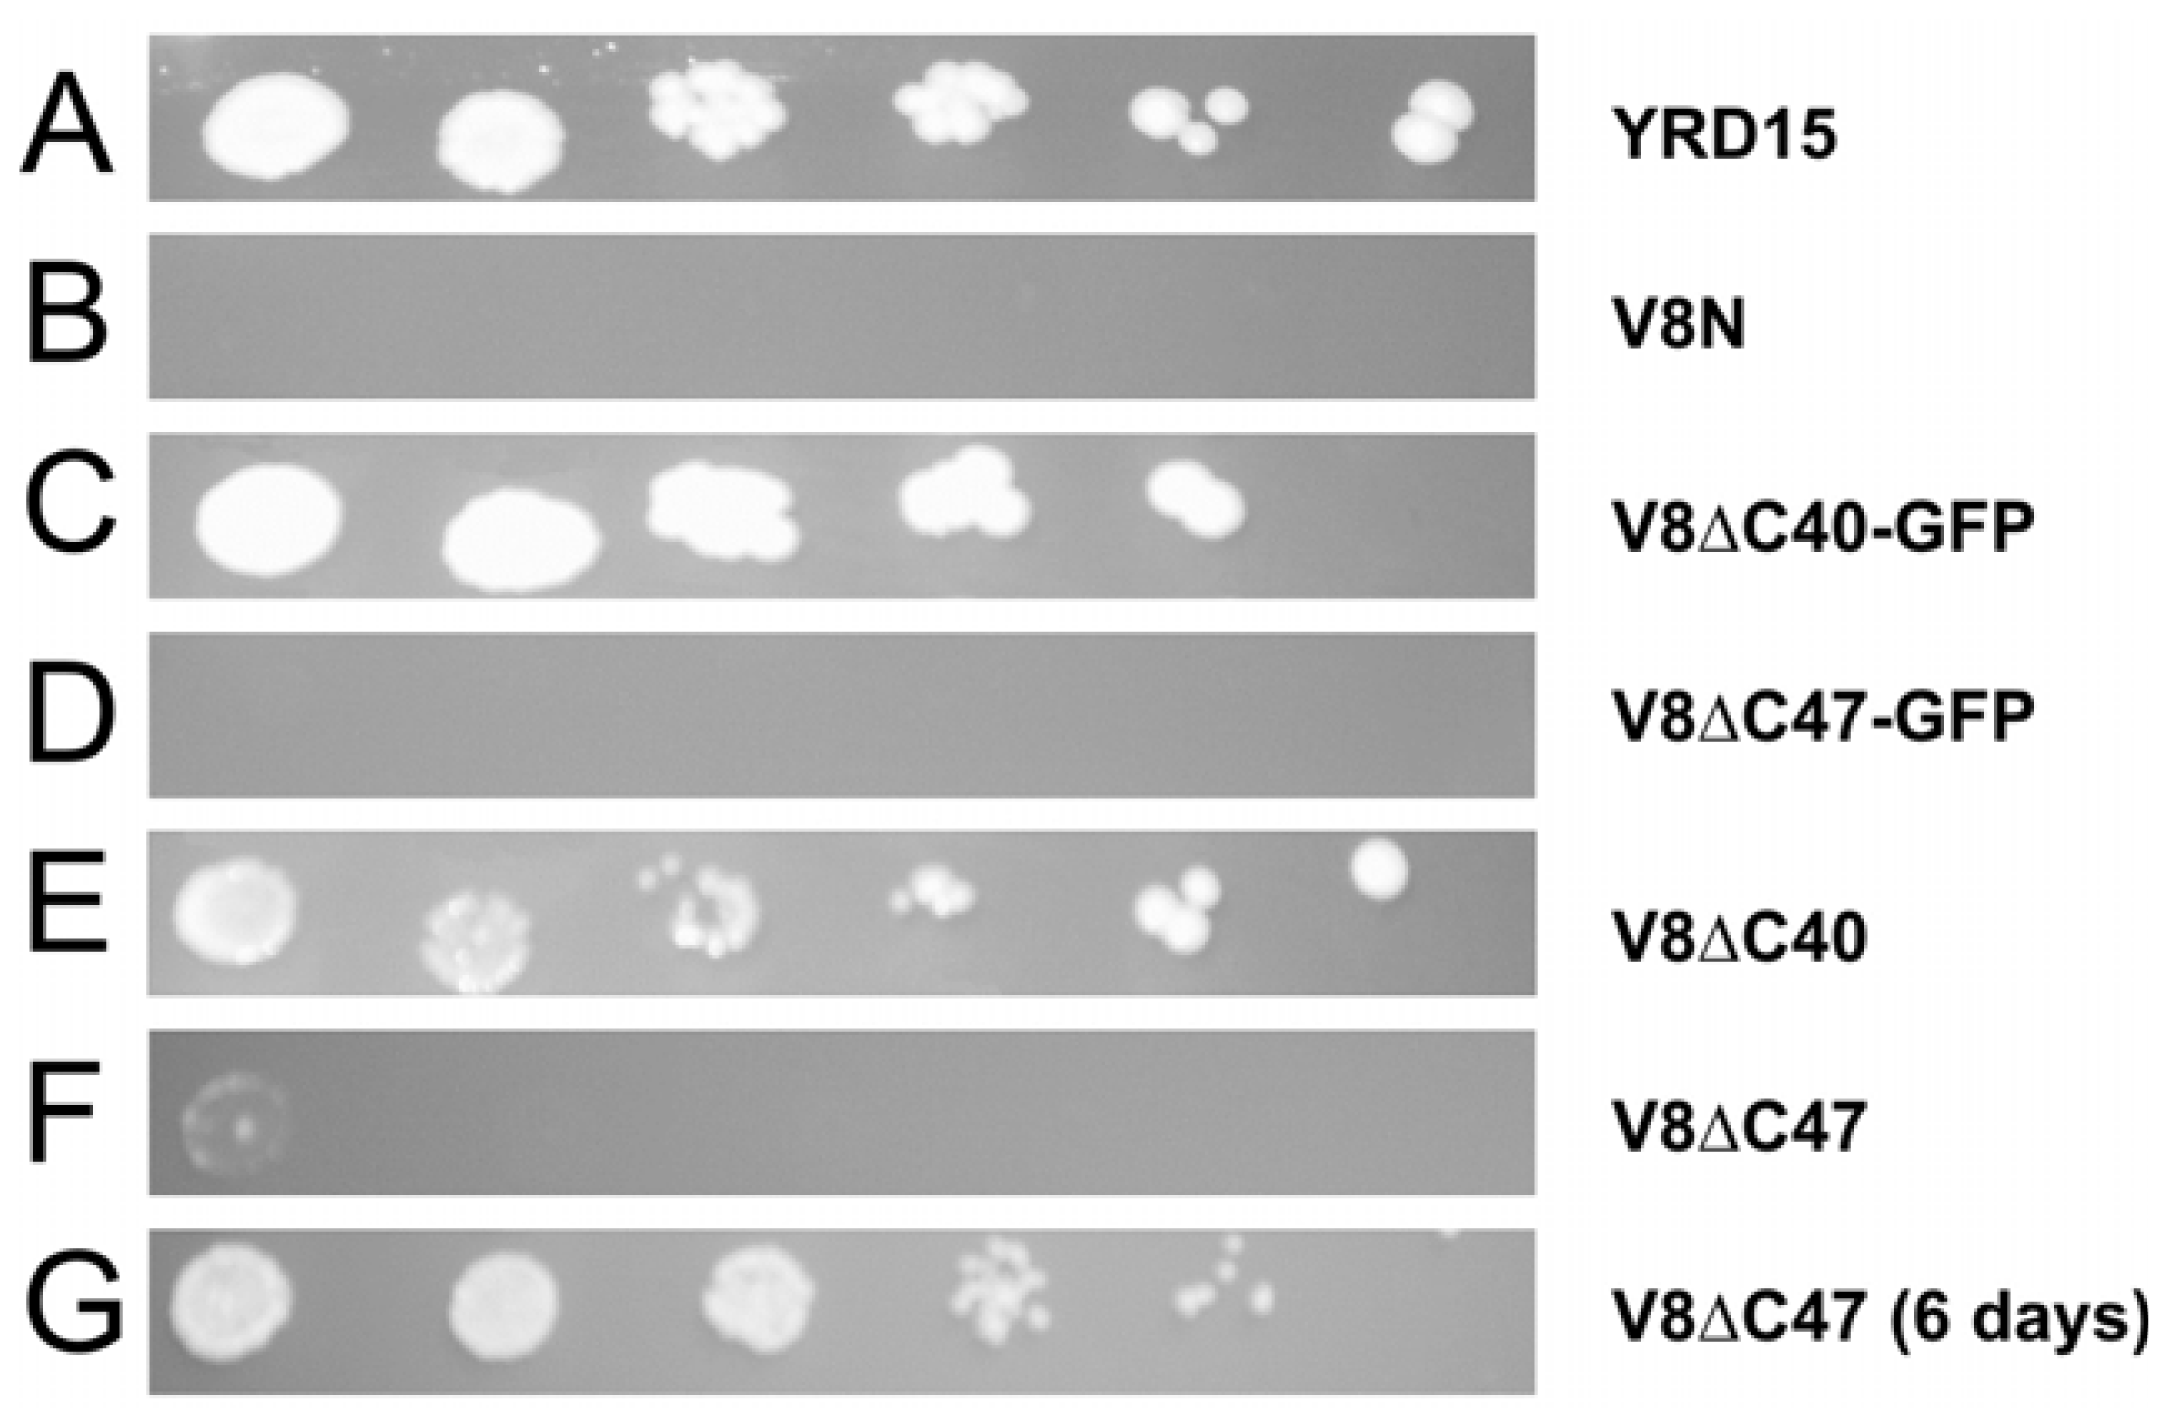
Ijms 12 04693f1

Vma8p-GFP Fusions Can Be Functionally Incorporated into V-ATPase, Suggesting Structural Flexibility at the Top of V1
Abstract
:1. Introduction
2. Results and Discussion
2.1. Experimental Strategy
2.2. Truncated Vma8p Variants Tagged with GFP are Functional
2.3. The Vma8p-GFP Fusion Proteins are Expressed Intact
2.4. Fluorescence Signals at the Vacuolar Membrane Indicate that the Fusion Proteins are Correctly Targeted and Folded
2.5. Vacuolar Uptake of Quinacrine in Vivo Indicates that V-ATPase Complexes Incorporating Vma8p-GFP Fusions are Functional
2.6. How Can a Vma8p-GFP Fusion Protein be Incorporated into Functional V-ATPase Complexes?
3. Experimental Section
3.1. Materials
3.2. Yeast Strains and Growth Media
3.3. Testing the Growth of Yeast Strains Expressing Vma8p Variants
3.4. Whole Cell Protein Extraction
3.5. Gel Electrophoresis and Western Blotting
3.6. Fluorescence Microscopy
3.7. Quinacrine Staining
4. Conclusions
Acknowledgements
References
- Arata, Y; Nishi, T; Kawasaki-Nishi, S; Shao, E; Wilkens, S; Forgac, M. Structure, subunit function and regulation of the coated vesicle and yeast vacuolar (H(+))-ATPases. Biochim. Biophys. Acta 2002, 1555, 71–74. [Google Scholar]
- Forgac, M. Vacuolar ATPases: Rotary proton pumps in physiology and pathophysiology. Nat. Rev. Mol. Cell Biol 2007, 8, 917–929. [Google Scholar]
- Graham, LA; Powell, B; Stevens, TH. Composition and assembly of the yeast vacuolar H(+)-ATPase complex. J. Exp. Biol 2000, 203, 61–70. [Google Scholar]
- Kane, PM. The long physiological reach of the yeast vacuolar H+-ATPase. J. Bioenerg. Biomembr 2007, 39, 415–421. [Google Scholar]
- Venzke, D; Domgall, I; Kocher, T; Fethiere, J; Fischer, S; Bottcher, B. Elucidation of the stator organization in the V-ATPase of Neurospora crassa. J. Mol. Biol 2005, 349, 659–669. [Google Scholar]
- Wilkens, S; Inoue, T; Forgac, M. Three-dimensional structure of the vacuolar ATPase. Localization of subunit H by difference imaging and chemical cross-linking. J. Biol. Chem 2004, 279, 41942–41949. [Google Scholar]
- Wilkens, S; Zhang, Z; Zheng, Y. A structural model of the vacuolar ATPase from transmission electron microscopy. Micron 2005, 36, 109–126. [Google Scholar]
- Hildenbrand, ZL; Molugu, SK; Stock, D; Bernal, RA. The C-H peripheral stalk base: A novel component in V1-ATPase assembly. PLoS One 2010, 5, e12588:1–e12588:9. [Google Scholar]
- Hirata, T; Iwamoto-Kihara, A; Sun-Wada, GH; Okajima, T; Wada, Y; Futai, M. Subunit rotation of vacuolar-type proton pumping ATPase: Relative rotation of the G and C subunits. J. Biol. Chem 2003, 278, 23714–23719. [Google Scholar]
- Imamura, H; Nakano, M; Noji, H; Muneyuki, E; Ohkuma, S; Yoshida, M; Yokoyama, K. Evidence for rotation of V1-ATPase. Proc. Natl. Acad. Sci. USA 2003, 100, 2312–2315. [Google Scholar]
- Cipriano, DJ; Wang, Y; Bond, S; Hinton, A; Jefferies, KC; Qi, J; Forgac, M. Structure and regulation of the vacuolar ATPases. Biochim. Biophys. Acta 2008, 1777, 599–604. [Google Scholar]
- Gruber, G; Wieczorek, H; Harvey, WR; Muller, V. Structure-function relationships of A-, Fand V-ATPases. J. Exp. Biol 2001, 204, 2597–2605. [Google Scholar]
- Zhang, Z; Charsky, C; Kane, PM; Wilkens, S. Yeast V1-ATPase: Affinity purification and structural features by electron microscopy. J. Biol. Chem 2003, 278, 47299–47306. [Google Scholar]
- Diepholz, M; Venzke, D; Prinz, S; Batisse, C; Florchinger, B; Rossle, M; Svergun, DI; Bottcher, B; Fethiere, J. A different conformation for EGC stator subcomplex in solution and in the assembled yeast V-ATPase: Possible implications for regulatory disassembly. Structure 2008, 16, 1789–1798. [Google Scholar]
- Zhang, Z; Zheng, Y; Mazon, H; Milgrom, E; Kitagawa, N; Kish-Trier, E; Heck, AJ; Kane, PM; Wilkens, S. Structure of the yeast vacuolar ATPase. J. Biol. Chem 2008, 283, 35983–35995. [Google Scholar]
- Muench, SP; Huss, M; Song, CF; Phillips, C; Wieczorek, H; Trinick, J; Harrison, MA. Cryo-electron microscopy of the vacuolar ATPase motor reveals its mechanical and regulatory complexity. J. Mol. Biol 2009, 386, 989–999. [Google Scholar]
- Numoto, N; Hasegawa, Y; Takeda, K; Miki, K. Inter-subunit interaction and quaternary rearrangement defined by the central stalk of prokaryotic V1-ATPase. EMBO Rep 2009, 10, 1228–1234. [Google Scholar]
- Lau, WC; Rubinstein, JL. Structure of intact Thermus thermophilus V-ATPase by cryo-EM reveals organization of the membrane-bound V(O) motor. Proc. Natl. Acad. Sci. USA 2010, 107, 1367–1372. [Google Scholar]
- Graham, LA; Hill, KJ; Stevens, TH. VMA8 encodes a 32-kDa V1 subunit of the Saccharomyces cerevisiae vacuolar H(+)-ATPase required for function and assembly of the enzyme complex. J. Biol. Chem 1995, 270, 15037–15044. [Google Scholar]
- Imamura, H; Ikeda, C; Yoshida, M; Yokoyama, K. The F subunit of Thermus thermophilus V1-ATPase promotes ATPase activity but is not necessary for rotation. J. Biol. Chem 2004, 279, 18085–18090. [Google Scholar]
- Tomashek, JJ; Graham, LA; Hutchins, MU; Stevens, TH; Klionsky, DJ. V1-situated stalk subunits of the yeast vacuolar proton-translocating ATPase. J. Biol. Chem 1997, 272, 26787–26793. [Google Scholar]
- Arata, Y; Baleja, JD; Forgac, M. Localization of subunits D, E, and G in the yeast V-ATPase complex using cysteine-mediated cross-linking to subunit B. Biochemistry 2002, 41, 11301–11307. [Google Scholar]
- Gregorini, M; Wang, J; Xie, XS; Milligan, RA; Engel, A. Three-dimensional reconstruction of bovine brain V-ATPase by cryo-electron microscopy and single particle analysis. J. Struct. Biol 2007, 158, 445–454. [Google Scholar]
- Xu, T; Forgac, M. Subunit D (Vma8p) of the yeast vacuolar H+-ATPase plays a role in coupling of proton transport and ATP hydrolysis. J. Biol. Chem 2000, 275, 22075–22081. [Google Scholar]
- Nelson, H; Mandiyan, S; Nelson, N. A bovine cDNA and a yeast gene (VMA8) encoding the subunit D of the vacuolar H(+)-ATPase. Proc. Natl. Acad. Sci. USA 1995, 92, 497–501. [Google Scholar]
- Abrahams, JP; Leslie, AG; Lutter, R; Walker, JE. Structure at 2.8 A resolution of F1-ATPase from bovine heart mitochondria. Nature 1994, 370, 621–628. [Google Scholar]
- Stock, D; Leslie, AG; Walker, JE. Molecular architecture of the rotary motor in ATP synthase. Science 1999, 286, 1700–1705. [Google Scholar]
- Prescott, M; Nowakowski, S; Gavin, P; Nagley, P; Whisstock, JC; Devenish, RJ. Subunit gamma-green fluorescent protein fusions are functionally incorporated into mitochondrial F1F0- ATP synthase, arguing against a rigid cap structure at the top of F1. J. Biol. Chem 2003, 278, 251–256. [Google Scholar]
- Anraku, Y; Hirata, R; Wada, Y; Ohya, Y. Molecular genetics of the yeast vacuolar H(+)-ATPase. J. Exp. Biol 1992, 172, 67–81. [Google Scholar]
- Wilkens, S; Vasilyeva, E; Forgac, M. Structure of the vacuolar ATPase by electron microscopy. J. Biol. Chem 1999, 274, 31804–31810. [Google Scholar]
- Wilkens, S. Personal Communication. Biochemistry and Molecular Biology, SUNY Upstate Medical University: Syracuse, NY, Italy, 2011. [Google Scholar]
- Tsien, RY. The green fluorescent protein. Annu. Rev. Biochem 1998, 67, 509–544. [Google Scholar]
- Devenish, RJ; Prescott, M; Turcic, K; Mijaljica, D. Monitoring organelle turnover in yeast using fluorescent protein tags. Methods Enzymol 2008, 451, 109–131. [Google Scholar]
- Kane, PM. Disassembly and reassembly of the yeast vacuolar H(+)-ATPase in vivo. J. Biol. Chem 1995, 270, 17025–17032. [Google Scholar]
- Roberts, CJ; Raymond, CK; Yamashiro, CT; Stevens, TH. Methods for studying the yeast vacuole. Methods Enzymol 1991, 194, 644–661. [Google Scholar]
- Straffon, AF; Prescott, M; Nagley, P; Devenish, RJ. The assembly of yeast mitochondrial ATP synthase: Subunit depletion in vivo suggests ordered assembly of the stalk subunits b, OSCP and d. Biochim. Biophys. Acta 1998, 1371, 157–162. [Google Scholar]
- Gavin, PD; Devenish, RJ; Prescott, M. An approach for reducing unwanted oligomerisation of DsRed fusion proteins. Biochem. Biophys. Res. Commun 2002, 298, 707–713. [Google Scholar]
- Prescott, M; Lourbakos, A; Bateson, M; Boyle, G; Nagley, P; Devenish, RJ. A novel fluorescent marker for assembled mitochondria ATP synthase of yeast. OSCP subunit fused to green fluorescent protein is assembled into the complex in vivo. FEBS Lett 1997, 411, 97–101. [Google Scholar]
- Gietz, RD; Woods, RA. Transformation of yeast by lithium acetate/single-stranded carrier DNA/polyethylene glycol method. Methods Enzymol 2002, 350, 87–96. [Google Scholar]
- Yaffe, MP. Analysis of mitochondrial function and assembly. Methods Enzymol 1991, 194, 627–643. [Google Scholar]

| Strain | Vma8p variant expressed | Molecular Mass (kDa) |
|---|---|---|
| YRD15 (wild-type) | Full Vma8p (residues 1-256) | 29.2 |
| V8N | No Vma8p expressed (gene deleted) | 0 |
| V8ΔC40-GFP | Residues 1 to 216 of Vma8p + GFP | 51.6 |
| V8ΔC47-GFP | Residues 1 to 209 of Vma8p + GFP | 50.8 |
| V8ΔC40 | Residues 1 to 216 of Vma8p | 24.7 |
| V8ΔC47 | Residues 1 to 209 of Vma8p | 23.9 |
© 2011 by the authors; licensee MDPI, Basel, Switzerland. This article is an open-access article distributed under the terms and conditions of the Creative Commons Attribution license (http://creativecommons.org/licenses/by/3.0/).
Share and Cite
Nowakowski, S.; Mijaljica, D.; Prescott, M.; Devenish, R.J. Vma8p-GFP Fusions Can Be Functionally Incorporated into V-ATPase, Suggesting Structural Flexibility at the Top of V1. Int. J. Mol. Sci. 2011, 12, 4693-4704. https://doi.org/10.3390/ijms12074693
Nowakowski S, Mijaljica D, Prescott M, Devenish RJ. Vma8p-GFP Fusions Can Be Functionally Incorporated into V-ATPase, Suggesting Structural Flexibility at the Top of V1. International Journal of Molecular Sciences. 2011; 12(7):4693-4704. https://doi.org/10.3390/ijms12074693
Chicago/Turabian StyleNowakowski, Szczepan, Dalibor Mijaljica, Mark Prescott, and Rodney J. Devenish. 2011. "Vma8p-GFP Fusions Can Be Functionally Incorporated into V-ATPase, Suggesting Structural Flexibility at the Top of V1" International Journal of Molecular Sciences 12, no. 7: 4693-4704. https://doi.org/10.3390/ijms12074693
APA StyleNowakowski, S., Mijaljica, D., Prescott, M., & Devenish, R. J. (2011). Vma8p-GFP Fusions Can Be Functionally Incorporated into V-ATPase, Suggesting Structural Flexibility at the Top of V1. International Journal of Molecular Sciences, 12(7), 4693-4704. https://doi.org/10.3390/ijms12074693
